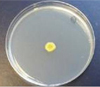

Новости LHC

Физики подводят промежуточные итоги изучения свойств хиггсовского бозона
21.09.2022

Работа коллайдера возобновится в ближайшие дни
19.09.2022

Работа коллайдера может быть продлена еще на несколько лет
04.09.2022

Неполадки в системе охлаждения на месяц задерживают работу коллайдера
30.08.2022
Картинка дня: Эволюция

Цветок хлоранта
28.07.2025 • Полина Сутягина
Библиотека: Эволюция
Архив новостей
По темам
Антропология, Арахнология, Археология, Астрономическая научная картинка дня, Астрономия, Астрофизика, Биоакустика, Биоинформатика, Биология, Биология развития, Биомеханика, Бионанотехнологии, Бионика, Биотехнологии, Биофизика, Биохимия, Ботаника, Видообразование, Вирусология, Вулканология, Генетика, География, Геология, Геофизика, Геохимия, Геронтология, Герпетология, Гидродинамика, Гляциология, Гравитационная линза, Демография, Дистанционное зондирование, Зарождение жизни, Затмения, Зоология, Иммунология, Информационные технологии, История, История науки, Ихтиология, Карцинология, Климат, Когнитивная наука, Космические исследования, Космология, Космос, Кристаллография, Лингвистика, Люди науки, Математика, Материаловедение, Медицина, Методология науки, Микология, Микробиология, Минералогия, Молекулярная биология, Нанотехнологии, Наука в России, Наука и общество, Наука и техника, Науки о Земле, Нейробиология, Нейроинформатика, Нейролингвистика, Нобелевские премии, Океанология, Онкология, Оптика, Орнитология, Палеогенетика, Палеонтология, Палеоэкология, Палеоэнтомология, Паразитология, Первое апреля, Политология, Почвоведение, Психология, Робототехника, Систематика, Социология, Стволовые клетки, Телескопы, Темная материя, Фармакология, Физика, Физиология, Физиология , Химия, Циркадные ритмы, Черные дыры, Эволюция, Эволюция галактик, Экзопланеты, Экология, Экономика, Эмбриология, Энергетика, Энтомология, Этнография, Этология
Свернуть
Все темы
По авторам
Айк Акопян, Евгений Амельченко, Валентин Анаников, Ольга Баклицкая-Каменева, Роман Балабин, Дарья Баранова, Вера Башмакова, Арсений Белосохов, Руслан Беляев, Александр Бердичевский, Александр Березин, Антон Бирюков, Светлана Бозрова, Алексей Бондарев, Максим Борисов, Варвара Бусова, Анастасия Вабищевич, Ольга Вахрушева, Варвара Веденина, Александр Венедюхин, Владимир Вержбицкий, Кирилл Власов, Михаил Волович, Эдуард Галоян, Михаил Гарбузов, Алексей Гиляров, Ольга Гилярова, Дмитрий Гиляров, Сергей Глаголев, Михаил Гопко, Евгений Гордеев, Анастасия Горелова, Николай Горностаев, Екатерина Грачева, Владимир Гриньков, Анна Гусева, Дмитрий Дагаев, Ира Демина, Екатерина Диффинэ, Татьяна Долгова, Мария Елифёрова, Иван Еребакан, Юрий Ерин, Анастасия Еськова, Дмитрий Жарков, Андрей Журавлёв, Дмитрий Замолодчиков, Никита Зеленков, Денис Земледельцев, Григорий Иванов, Игорь Иванов, Сергей Измалков, Вячеслав Калинин, Андрей Карпачевский, Анна Каспарсон, Павел Квартальнов, Екатерина Киреева, Анастасия Кириллова, Мария Кирсанова, Дмитрий Кирюхин, Галина Клинк, Дмитрий Кнорре, Александр Козловский, Сергей Коленов, Кирилл Колесников, Людмила Колупаева, Юлия Кондратенко, Андрей Коньков, Артём Коржиманов, Ольга Кочина, Юлия Краус, Леонид Кузьмин, Владимир Кукулин, Георгий Куракин, Аркадий Курамшин, Виталий Кушниров, Иван Лаврёнов, Надежда Лапина, Алексей Левин, Дмитрий Леонтьев, Иван Логашенко, Андрей Логинов, Полина Лосева, Сергей Лысенков, Анастасия Макарова, Лейла Мамирова, Александр Марков, Даниил Марков, Александр Марфин, Мария Медникова, Елизавета Минина, Александр Мироненко, Юлия Михневич, Вадим Мокиевский, Григорий Молев, Тарас Молотилин, Антон Морковин, Марат Мусин, Вера Мухина, Эдуард Мычко, Максим Нагорных, Елена Наймарк, Влад Начатой, Антон Нелихов, Михаил Никитин, Анна Новиковская, Хайдар Нурлигареев, Алексей Опаев, Михаил Орлов, Алексей Паевский, Андрей Панкратов, Анастасия Пашутова, Пётр Петров, Александр Пиперски, Константин Попадьин, Сергей Попов, Наталья Прилепская, Андрей Райгородский, Роман Ракитов, Жанна Резникова, Татьяна Романовская, Константин Рыбаков, Анна Сабурова, Александр Самардак, Наталия Самойлова, Вероника Самоцкая, Елена Сейфина, Иван Семенков, Александр Сергеев, Александр Сигеев, Андрей Сидоренко, Илья Скляр, Виктория Скобеева, Даниил Смирнов, Павел Смирнов, Олег Соколенко, Дарья Спасская, Михаил Столповский, Владислав Стрекопытов, Любовь Стрельникова, Дмитрий Сутормин, Алёна Сухопутова, Алексей Тимошенко, Ольга Титова, Александр Токарев, Кристина Уласович, Антон Ульяхин, Елена Устинова, Андрей Фельдман, Ольга Филатова, Александр Храмов, Вера Шейкина, Мария Шнырёва, Анна Шумовская, Илья Щеглов, Динар Юнусов, Александр Яровитчук, Светлана Ястребова, Сергей Ястребов
Свернуть
Все авторы
По месяцам
Свернуть
Все даты
Видеотека
 1:09:40
1:09:40
Александр Аверьянов
Развитие млекопитающих в мезозое
Лекторий Культурно-просветительского центра «Архэ»_СПБ • 29.04.2025